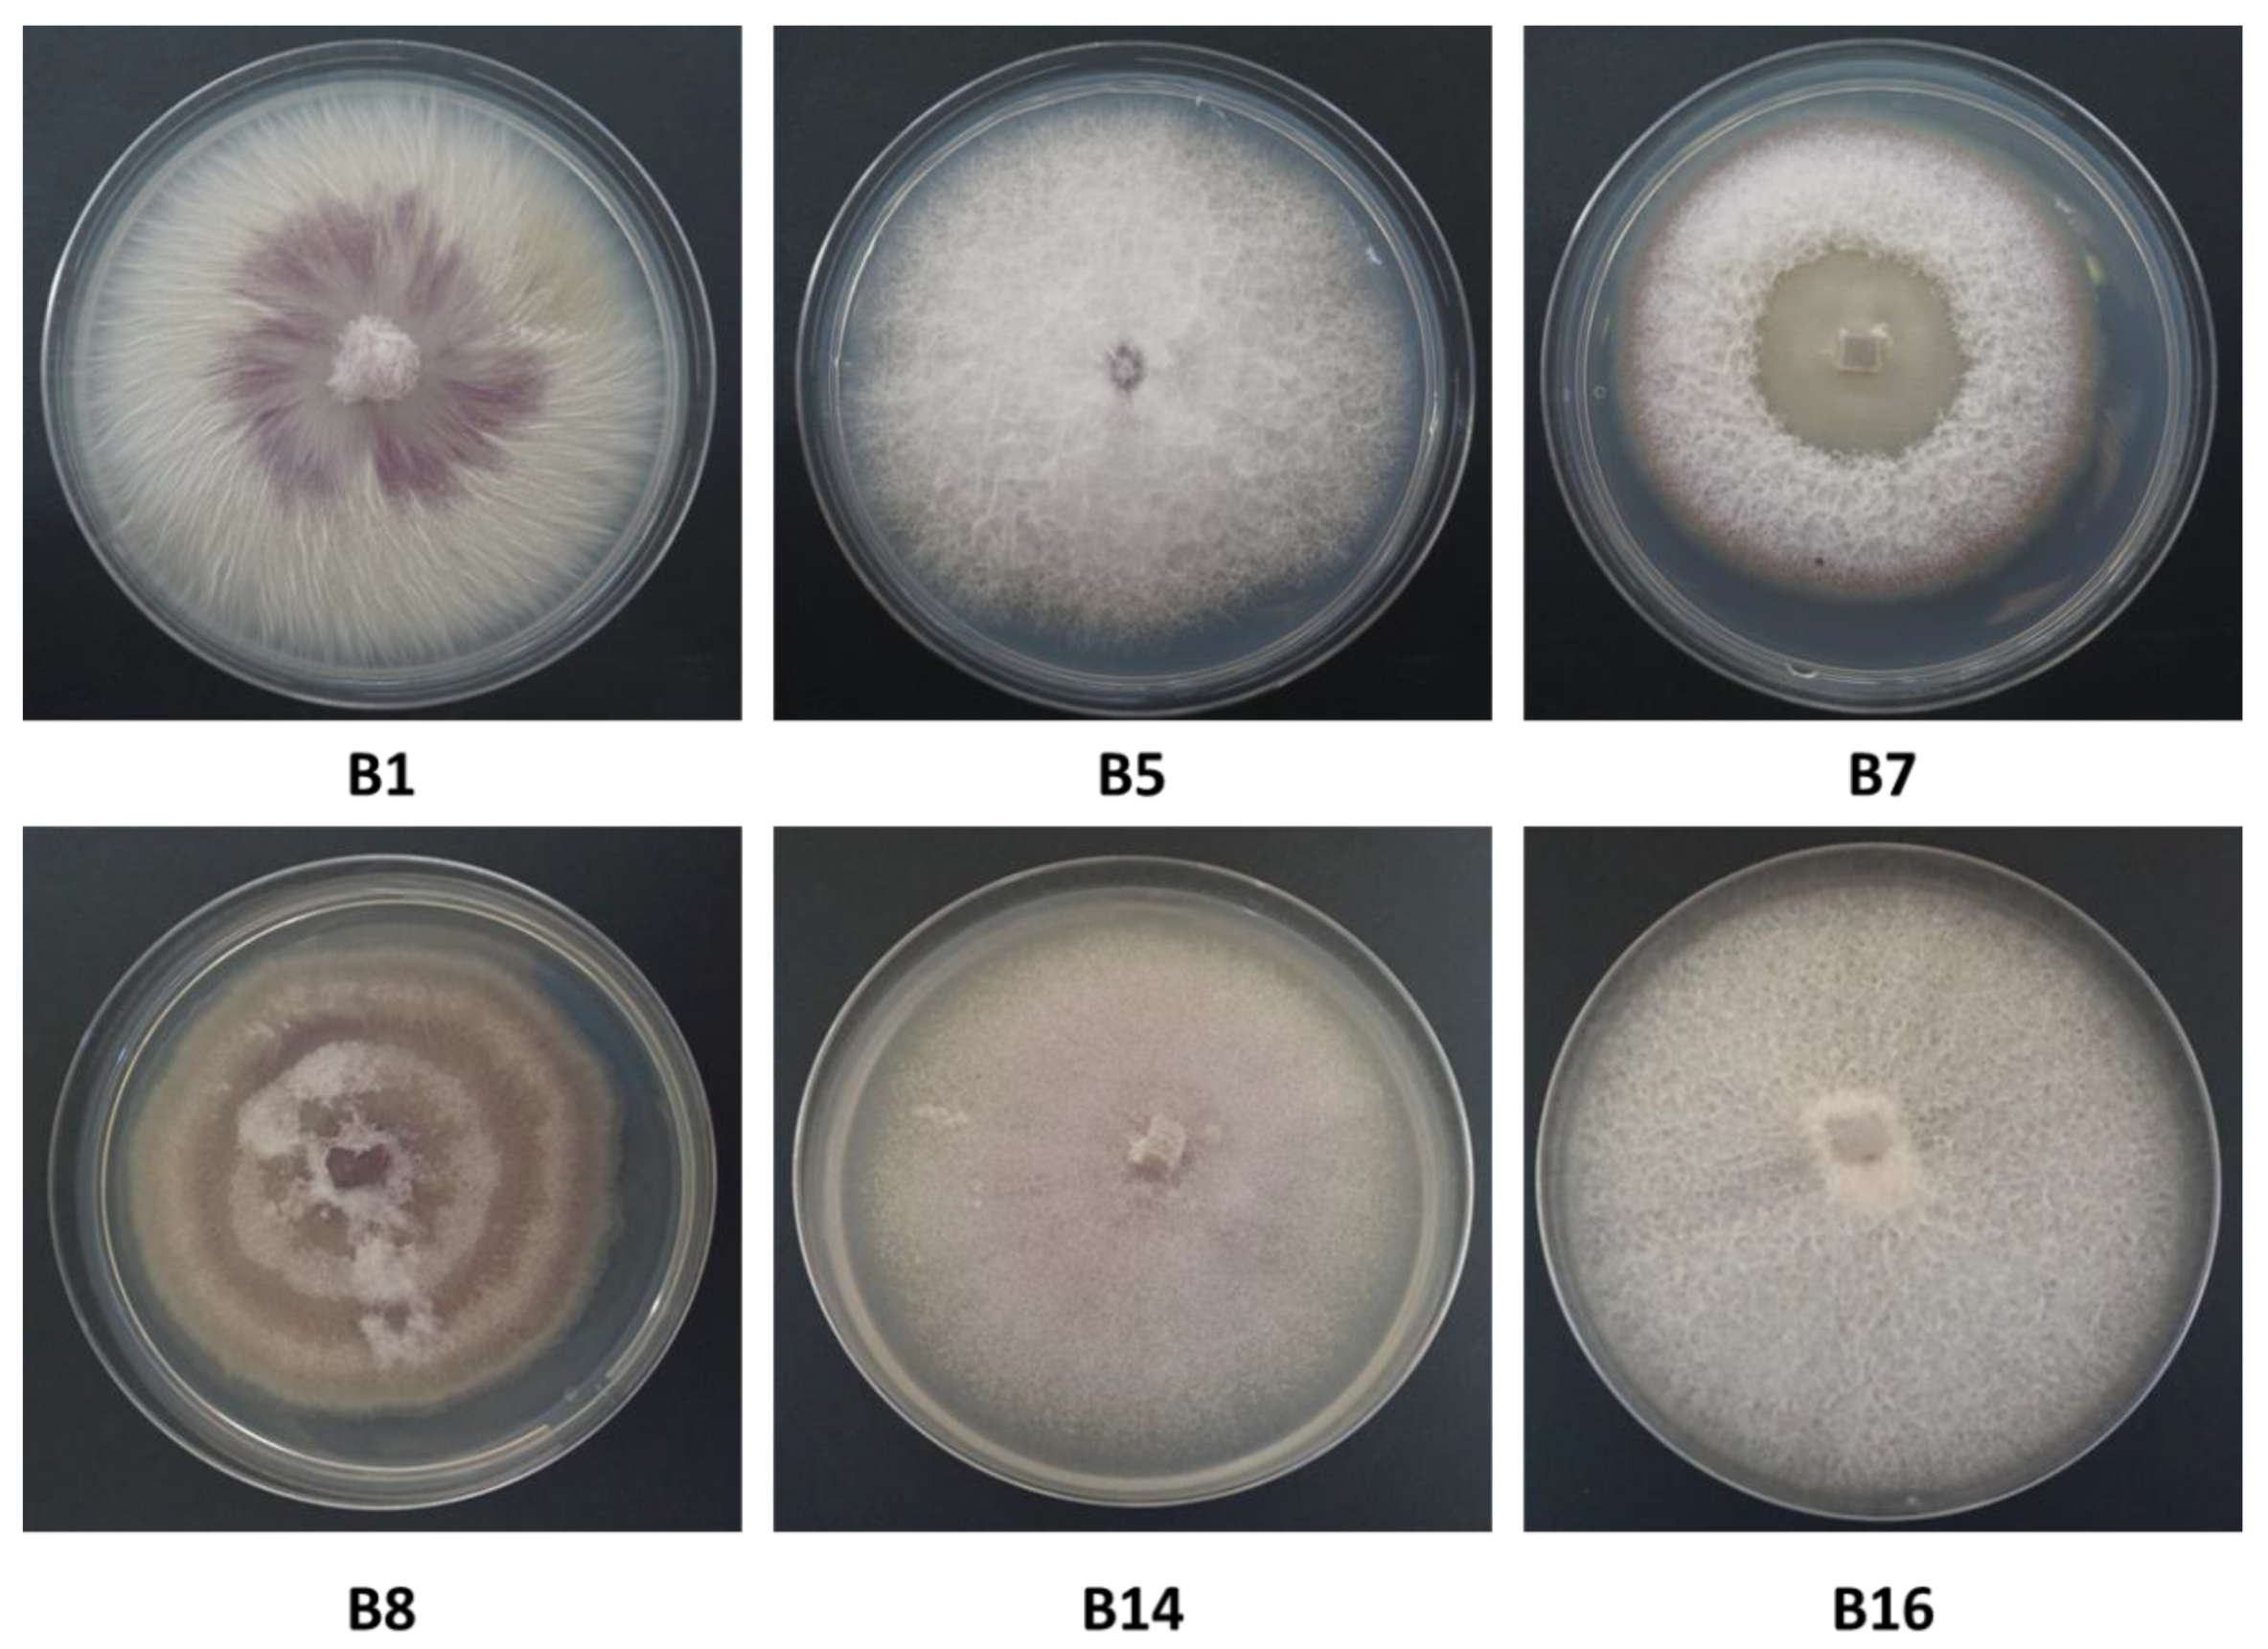
Biology 09 00069 g004

1. Introduction
Onion (
Allium cepa L., a member of the Amaryllidaceae family, also known as the bulb onion or common onion) is one of the most commonly grown and consumed vegetable crops in the world and is an important crop in Israel, grown during the winter–spring and harvested during the hot summer. In 2013, onion bulb production in Israel covered an area of ca 2500 ha throughout the country [
1]. In 2017, the commercial production of onion bulbs for the local markets reached ca. 47,000 tons (9% of the bulk fresh vegetables according to data from the Israel Ministry of Agriculture and Rural Development). Species of the fungus genus
Fusarium are widely distributed in soils in all climatic zones around the globe, associate with a vast diversity of plants, and cause severe plant diseases in crops [
2]. Some members of this genus are responsible for diseases that have a significant economic impact in several onion-growing countries [
3]. Wilting of onion plants with rot in the roots and basal plate of the bulb has been related mostly to
Fusarium oxysporum f. sp.
cepae [
4], but formae speciales (f.sp., a group of isolates that are pathogenic to particular host plants) of
Fusarium solani are also common in the roots of onions and cause plant wilting [
5]. In addition,
Fusarium proliferatum was more recently reported as the predominant fungal species isolated from the roots and bulbs of onion and garlic plants [
6].
Pathogenic
F. oxysporum is defined as one of the world’s most damaging plant pathogens [
7]. It is a common soil-borne pathogen that has an exceptional level of host specificity with over 120 different formae speciales [
8].
F. oxysporum f. sp.
cepae causes severe disease in onions, with recorded yield losses of more than 50% [
4]. Chlamydospores, produced by the older mycelium, enable
F. oxysporum f. sp.
cepae to survive in the absence of its host in the soil for a very long time.
Fusarium proliferatum is related to
Fusarium oxysporum f. sp.
cepae and
Fusarium culmorum but can be distinguished from these species based on morphology, and, to some extent, symptoms on the hosts.
F. proliferatum can survive for extended periods in soil, so it is best to avoid planting the same field repeatedly with either onion or garlic [
9].
F. proliferatum was reported in onion in different countries, including the United States [
10], Serbia [
6], Argentina [
11], The Netherlands, Uruguay [
12], Sweden [
13], and Germany [
14].
The accumulated knowledge of farmers in northern Israel and the Extension Service indicates that, in infested soil, there is an increasing risk of reduced seed germination and the appearance of onion basal rot throughout the growing season until harvest. According to these cumulative data, high temperatures before and during bulb maturation are optimal for fungus infiltration, establishment, and spread in the field. The onset of the disease usually appears as individual diseased plants or diseased patches in the field, and not in the entire field. Over time, the spread of the disease increases, more patches appear in the field, and the entire field can be affected. Crop protection methods are currently based on a four-year crop cycle and general soil disinfection with metam sodium before sowing.
Onion basal rot disease has been recognized in Israel for many years, causing about 1% yield loss in the fields (data from the Israel Ministry of Agriculture and Rural Development, and the Extension Service). However, the effect on yield and bulb quality has led to reduced growing areas and economic losses. Infected onions do not always show external disease symptoms, and if they reach storage, the problem is considerably worsened. When stored in open sheds or packing houses, the disease can soon spread to the rest of the onions. Moreover, there is concern that infected bulbs without visual symptoms will reach markets across the country. This concern is heightened by the presence of known toxins secreted by these pathogens [
6]. Significant gaps of knowledge currently exist in Israel regarding the nature and distribution of the disease, the causal pathogens, and effective measures of control. Specifically, no disease-resistant onion cultivars have been recognized, and no fungicides have been proven to be unequivocally efficient and useful against the pathogen.
The growing number of reports in the past decade from local Israeli growers and consultation service personnel on onion root and bulb rot is a significant concern. Abraham Gamliel et al. (Southern Arava R&D annual report) reported in 2013 on an
F. proliferatum disease outburst in white onions from different fields in the southern Arava area (southern Israel), probably caused by planting infected bulbs. Similar phenomena were reported in lily (
Lilium longiflorum) and
F. proliferatum (white and purple isolates), as well as
Fusarium oxysporum were identified [
1] as the causative agents. Subsequent pathogenicity trials conducted on lily bulbs and onion seedlings in growth chambers fulfilled Koch’s postulates and proved that the most pathogenic fungus was
F. proliferatum (white isolates). Still, the disease in the Golan Heights in northeastern Israel has not been studied, and no data exist on the mycoflora of infected onion plants in this area. Thus, the objectives of the present study are to identify and characterize the causal agents of onion root and bulb rot in plants grown in commercial fields in this region of the country.
2. Materials and Methods
2.1. Isolation and Identification of Pathogens from Diseased Onion Plants
The study focused on two common varieties, Riverside (Orlando) cv. (white onion) and 565/505 cv. (red onion) (supplied by Hazera Seeds Ltd., Berurim MP Shikmim, Israel). Onion bulbs from commercial fields located in the Golan Heights (northeastern Israel) were analyzed for infestation with Fusarium species. Random samples of diseased onion plant parts, including onion roots and bulbs, were collected from two commercial fields at the end of the 2017 summer growing season (Kibbutz Ortal, northern Golan Heights) and the 2018 spring season (Moshav Eliad, southern Golan Heights). Bulbs were washed thoroughly under tap water, and the infected tissue of the roots and basal plate was separated using a scalpel. The tissue was cut into small segments (approximately 5 mm long), and each piece was surface-sterilized by dipping it in 70% alcohol for a few seconds, followed by immersion in 1% sodium hypochlorite for 1 min and then washing twice in sterile double-distilled water (DDW). After drying the tissue on a sterile paper towel in a fume hood, the bulb basal plate segments were plated on potato dextrose agar (PDA; Difco Laboratories, Detroit, MI, USA) medium supplemented with 2.5 mg/mL chloramphenicol. After incubation of the Petri dishes for 2–3 days at 28 ± 1 °C in the dark, the fungi started to grow from the tissue and were separated and transferred to a new plate. In order to obtain a pure colony, the single-spore subcultures method was used.
Cultures were propagated from single conidia, as follows. A 6-mm-diameter culture disc was transferred from each of the inspected isolates to a 15-mL test tube with DDW. After thorough vortexing, seeding of the fungus was performed by diluting the suspension up to a concentration of 1–5 spores per 5 µl. Spore counting using a Fuchs-Rosenthal counting chamber was done with a light microscope equipped with a Moticam 5 camera (Motic Instruments, Richmond, Canada). Then, 5 µl of each suspension was transferred to PDA plates and dispersed using a Drigelski stick. After two days of incubation in the dark at 28 ± 1 °C, the fungus grew on the new PDA plates. These colonies served as a single pure genetic source (common genetic origin) for further research. In this way, a total of 13 isolates was obtained. The isolates were divided into subgroups with identical colony characteristics, and representative fungal isolates from each group were selected and classified using taxonomic keys, including colony structures and macroscopic characterization. Fusarium spp. isolates were also molecularly identified as detailed below. In order to assess each isolate colony growth rate, radial mycelial growth was taken at two-day intervals (2, 4, 6, and 8 days) after inoculation by measuring the diameter along two perpendicular lines from the underside of the Petri dishes.
2.2. Microscopy
For microscopic observation of hyphae and spores formation, all isolates were grown on PDA plates for four days. Mycelial mats or conidia were scraped off the plate, and a small amount was suspended in 10 µl potato dextrose broth (PDB) or DDW and placed on sterile glass slides for microscopy observation. In order to maintain the integrity of the fragile fungal reproductive structures, the fungal slide culture technique [
15] was used. A block of inoculated nutrient agar (taken from 2–4-day-old PDA colony) sandwiched between two sterile cover glass slides was placed in a plastic Petri dish containing water agar. The dishes, covered and sealed with parafilm, were incubated for 3–4 days at 28 ± 1 °C in the dark. The new hyphae and fungal reproductive structures were observed and photographed using a light microscope equipped with a Moticam 5 camera. The microscope magnification was 250:1, and no stain was used.
2.3. Isolation and Purification of Fungal DNA and PCR Amplification
Mycelia from PDA-grown colonies were used for DNA extraction using the Master Pure Yeast DNA Purification Set Kit (Sigma, Rehovot, Israel). Molecular identification by PCR and sequencing was made by targeting the
Fusarium translation elongation factor-1 alpha (TEF1) gene and the fungus T12 beta-tubulin gene, as well as the small subunit ribosomal RNA gene, universal internal transcribed spacer (ITS). The
Fusarium oxysporum f. sp.
cepae (FOC) secreted in xylem genes 3 (SIX3, [
16]) was used to determine whether the
F. oxysporum samples belong to formae speciales
cepae. The partial calmodulin gene sequence (CLPRO, [
17]) was used to identify the
Fusarium proliferatum isolate. Final confirmation of similarities between the isolates was achieved by the inter simple sequence repeat (ISSR)–PCR molecular method. The ISSR–PCR molecular technique provides a quick, reliable, and highly informative system for DNA fingerprinting using microsatellite sequences as PCR primers (
Table 1), to generate multilocus markers [
18]. DNA markers were amplified using the primer sets described in
Table 1. The specific identification of
F. oxysporum f. sp
cepae was made using new primers designed in this work. The FOC–SIX3 was designed using Primer3Plus software (
http://primer3plus.com) on a region of the SIX3 coding sequence common to
F. oxysporum f. sp
cepae and
Fusarium oxysporum f. sp.
lycopersici.
PCR was done using the Rapidcycler (Idaho Technology, Salt Lake City, Utah 84108, USA) in a total volume of 20 μL per reaction: 1 μL of each primer (concentration of 20 μM), 10 μL of commercial reaction mixture: RedTaq
® ReadyMix (Sigma, Rehovot, Israel), 3 μL of template DNA and 5 µl autoclaved DDW. PCR conditions: 94 °C for 2 min, 30 rounds of 94 °C for 30 s, 55 °C for 30 s, 72 °C for one minute, and a finishing step of 72 °C for 5 min [
19]. For the FOC–SIX3 amplification, PCR reactions were performed using the following conditions: denaturation at 95 °C for 5 min; 35 cycles of denaturation at 95 °C for 15 sec, annealing at 61 °C for 15 sec, extension at 72 °C for 15 sec; final extension at 72 °C for 10 min, followed by cooling at 12 °C until recovery of the samples. For CLPRO amplification, PCR reactions were performed using the following conditions: denaturation at 95 °C for 5 min; 35 cycles of denaturation at 95 °C for 50 sec, annealing at 56 °C for 50 sec, extension at 72 °C for 1 min; final extension at 72 °C for 7 min, followed by cooling at 4 °C until recovery of the samples. For size determination and gel purification prior to sequencing, the PCR products were separated on 1.5% agarose gel electrophoresis (Lonza, Rockland, USA), and afterward sequenced (Hy Labs, Rehovot, Israel).
2.4. Identification of the Fusarium Species and Phylogenetic Relationships
Sequences were used to conduct a homology search against the GeneBank using the BLASTN tool [
24] (nucleotide blast on the NCBI website,
https://blast.ncbi.nlm.nih.gov/Blast.cgi,
Table 2). Sequences were aligned using the Clone Manager 10.0 program (Sci Ed Software, Durham, NC, USA). The alignment of the TEF1 gene was used to construct a phylogenetic tree. The SeaView version 5.0 program (
http://doua.prabi.fr/software/seaview) was used to generate a phylogenetic tree. The phylogenetic tree was performed using bootstrap with 1000 replicates and excluded positions with gaps.
2.5. Seedling Pathogenicity Assay
The pathogenicity test on onion seedlings was designed to measure the level of virulence of the Fusarium spp. isolates. The test was repeated twice with six replicates (Petri dishes with 10-15 seeds each). The Riverside (Orlando) cv. (white onion) and Noam cv. (red onion, supplied by Hazera Seeds Ltd., Berurim MP Shikmim, Israel) seeds were rinsed in DDW, soaked in NaOCl 1% for 1 min, and rinsed again twice in DDW. Each group of onion seeds was transferred to a Petri dish in which sterile Whatman paper was soaked in water. The seeds were inoculated with a 6-mm-diameter disc cut from a 5-day Fusarium sp. colony, grown previously on PDA, in the dark, at 28 ± 1 °C. A sterile 6-mm-diameter PDA disc was added to the control group. Sterile tap water was added to each plate every three days to maintain moisture and to allow efficient germination and disease progression. After nine days of incubation in the dark, at 28 ± 1 °C, the seeds were photographed, washed, and their germination percentages, sprout biomass, and hypocotyl length were measured. A germinating seed was defined as a seed in which the seed coat was broken by the radicle.
2.6. Onion Bulb Pathogenicity Assay
For the Koch’s postulates accomplishment, an onion bulb pathogenicity assay was conducted on Riverside (Orlando) cv. and Noam cv. (white and red onion cultivars, respectively). The entire assay was performed in six repetitions per isolate in a sterile environment within a biological hood. From each isolate, a stock of 106 spores/mL (in sterile water) was prepared from a five-day-old colony grown previously on a PDA at 28 ± 1 °C in the dark. After removing the outer scales, the bulbs were sterilized in 70% ethanol and dried. Inoculation was done by stabbing the basal plate with a sterile pipette tip (10 mm in diameter) five times in different areas at a depth of 5 mm. Fifty µl spores were pipetted into each puncture, while a similar volume of sterile water was injected into the control bulbs. Each bulb was kept individually in a closed sterilized plastic bag to maintain a moist environment and prevent unwanted contamination, in a temperature-controlled incubator in the dark at 28 ± 1 °C. After two weeks of incubation, external and internal disease symptoms were photographed and evaluated qualitatively, and the fungus from each infected onion was re-isolated on PDA and identified to satisfy Koch’s postulates.
2.7. Statistical Analysis
A fully randomized statistical design was used in all experiments. Statistics and data analysis were carried out using the JMP program, 7th Edition, SAS Institute Inc., Cary, NC, USA. Disease symptoms were analyzed by one-way ANOVA followed by post-hoc multiple comparisons of Student’s t-test for each pair. The t-test was conducted with a significance threshold of p = 0.05 to compare the treatment means to those of the control.
4. Discussion
Plant diseases caused by fungi destroy or contaminate a significant proportion of global agricultural production, making fungi the most deleterious class of plant pathogens [
27]. Onion bulb rot is an economically significant disease that has emerged in Israel and other countries. This study identified different
Fusarium species as the causal agent, and it adapted tools to identify the fungi and assay isolate virulence, as well as enable the screening of onion germplasm for resistance. The morphological characteristics of
Fusarium spp. have been used in the past as the preferred methods for species identification [
28]. However, the
Fusarium genus is complex, and morphological differences may be challenging to observe. Therefore, DNA analysis is needed for accurate identification and characterization of the species. Isolates of the
Fusarium spp. obtained from rotting bulbs of onion plants in commercial fields in northeastern Israel could not be differentiated morphologically from
Fusarium strains found in other parts of Israel [
1], and in other countries as well [
25,
26]. The DNA-sequence-based approach identified four
Fusarium species among our field-collected samples:
F. proliferatum,
F. oxysporum f. sp.
cepae, and two other species (less familiar as onion bulb rot causal agents),
F. acutatum and
F. anthophilium. The identity of the four species as the causal agents of onion bulb rot and onion seedlings disease was predominantly approved here using Koch’s postulates. This agrees with a previous report that the white strain of
F. proliferatum is the most virulent causal agent in southern Israel, causing apperent symptoms in onion seedlings [
1].
Since different
Fusarium species were isolated from two different fields (in the north and south of the Golan Heights) and from two white and red onion cultivars (
Table 2), each area or cultivar may harbor a unique mycobiome, as illustrated by the phylogenetic tree (
Figure 6). Moreover, the onion bulb pathogenicity assay suggests that variation exists in disease sensitivity between cultivars. For example, Noam cv. being more resistant to some of the onion basal rot disease-causing agents, than Riverside cv. (
Figure 9). It should be taken into consideration that several other factors may be involved in the two unique mycoflora separations. For example, the identification of different species in the two cultivars may be related to geographic factors (soil conditions, environmental conditions). Alternatively, anthocyanins and other pigments may influence plant–pathogen interactions, as well as disease resistance. These interesting variations should be examined more thoroughly in future studies. The seedling pathogenicity assay identified all
Fusarium isolates as being able to significantly impact seed germination rate, hypocotyl elongation, and fresh biomass.
The increase in germination percentages in the presence of some of the isolates in the plate assay (B8, B14, and B16) may not reflect well the emergence inhibition in the plates. As seen clearly in
Figure 7, there are variations among the seeds of the same treatment. Some have a very small radicle with no hypocotyl. In contrast, others have a well-developed radicle and hypocotyl. Thus, the hypocotyl elongation and fresh biomass better represent the influence of the pathogen under these conditions. Still, the interactions between those species should be studied to identify possible competition, antagonism, or synergism, as demonstrated in other cases [
29]. Some of these
Fusarium species may be less competitive pathogens or secondary parasites. Understanding the relationships within the fungal community involved in onion basal rot is essential for developing a preventive intervention program and should be examined more closely in subsequent work.
Onion bulb basal rot caused by the soil fungi
F. oxysporum and
F. proliferatum presents an increasingly severe threat to onion production in Israel [
1]. A possible reason for the increased incidence of the disease in recent years could be the use of infected seeds for sowing. These two species were present in a substantial proportion of onion samples with basal rot originating from different continents [
12]. Nevertheless, today there are only a few methods to control
Fusarium basal rot diseases in commercial fields in Israel. Such practices include soil solarization [
30], four-year crop rotation for onions, including avoidance of other members of the lily family, and breeding alliaceous crops for pest resistance [
3]. In addition, using fludioxonil, thiophanate methyl [
9], or metam sodium (formally a dithiocarbamate used for soil disinfection) as a pre-planting dip can provide some protection. However, contaminated agricultural equipment (e.g., plows) and workers facilitate disease spread to new areas. Indeed, the spread of the disease in Israel is unequivocally increasing, with reports of the fungus and disease symptoms in new agricultural regions with no previous disease record.
The onion seedling and bulb pathogenicity assay that was adjusted and used in the current work may be useful for breeding onion cultivars resistance and for screening fungicides, as was done in other crop fungal diseases (see, for example, [
31]). Also, this assay may enable us to examine other treatments and to study the penetration and establishment stages of the pathogenesis. A scientific program dedicated to developing disease control cannot be established exclusively on field experiments during the growing season. This is due to the considerable investment involved in such experiments, the long period until results are received, and the fluctuations in environmental conditions that cause inconsistency in the results. The difficulty in receiving consistent and repeatable results is enhanced by the non-uniform, scattered nature of the
Fusarium onion basal rot disease. Both the onion seedlings and bulbs pathogenicity assays offer a fast, reliable, and consistent solution to this problem. It is important to combine those two assays in order to achieve a more accurate prognostication about the aggressiveness of the pathogens involved in the onion basal rot disease. Despite these diagnostic methods’ advantages, they should be considered in a critical manner. Controlled-condition assays and even a seedlings pot assay are, in many cases, inconsistent in their ability to predict results in the field [
32]. Still, they are necessary preliminary steps in ruling out ineffective treatments and in choosing the ones having the highest probability to succeed. A pot assay for screening fungicides to control the onion basal rot disease should be the focus of a subsequent study.
Infected onions without any previous symptoms in the field were also reported [
13], suggesting post-harvest disease development. Indeed,
F. oxysporum f. sp.
cepae caused basal rot during lengthy storage [
12]. Moreover,
Fusarium infections result in contamination with mycotoxins, some of which have a notable impact on human and animal health [
33]. The two most prevalent
Fusarium spp. on diseased onion bulbs reported in this and previous studies [
1],
F. oxysporum and
F. proliferatum, can produce mycotoxins such as enniatins, fumonisins, moniliformin, and fusaric acid [
6]. Thus, the gradual increase in the incidence of onion yield loss due to
Fusarium basal rot disease urgently requires the development of new approaches to restrict the pathogen outburst and spread.
The two above-mentioned Fusarium spp., F. proliferatum (isolated from white onion, Riverside cv.) and F. oxysporum f. sp. cepae (isolated from 565/505 cv., a newly developed red onion), are known as primary causal agents of basal rot, and given their pathogenic interaction with the onion found in this research, we can assume that these fungi are significant contributors to the disease. Regarding the other two Fusarium species identified in the diseased onion samples, F. acutatum and F. anthophilium, it is still not clear to what extent these species can exclusively cause disease in onions, or if the onion is merely used as an alternative host. Nevertheless, all four Fusarium species were pathogenic to the onion cultivar inspected here.
This study on the mycoflora that causes onion basal rot disease in northeastern Israel has implications beyond the local scale and may contribute to onion producers in other regions. Others can follow the methodology used here. It may help to distinguish between the Fusarium species involved, which can be challenging due to the rapid changes of this particular pathogen genus. It would be important to expand the research on the threat caused by Fusarium on onion to other plant species in different countries and continents.